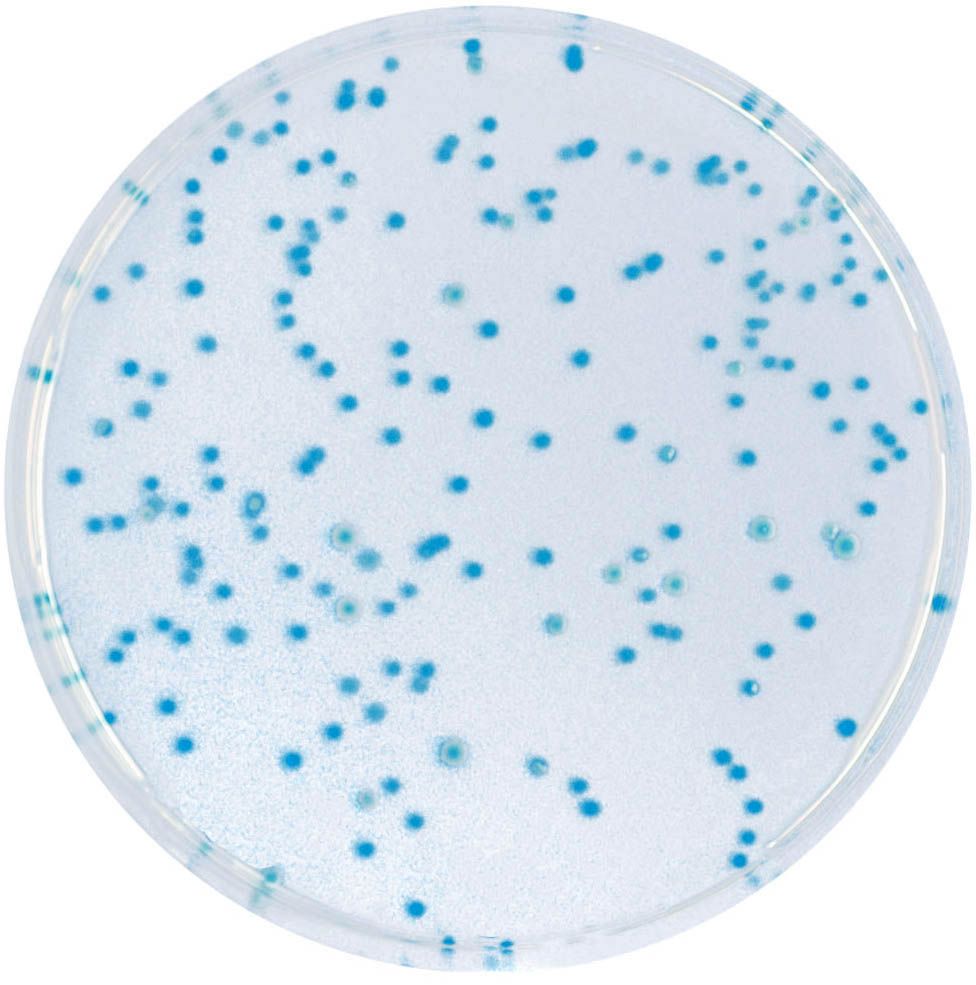
CHROMagar™ E.coli - 25 L

EF343-500G
NEW PACKAGE SIZE
Same price per g
For the simultaneous detection and enumeration of E. coli and other coliforms in water samples according to ISO9308-1 norm
Package size: 500 g
DKK 7.140,00
DKK 9.750,00
Not in stock, delivery 1-2 weeks
Chromogenic medium for detection and enumeration of ß-glucuronidase positive E. coli in food, water and environmental samples.
The product is composed of one single powder medium.
MEDIUM PERFORMANCE:
1. 24 h detection.
2. Easy reading and interpretation: The general food and water standards limits are usually zero to single figure E. coli cfu per gram and thus it is important to detect and enumerate them accurately. With CHROMagar™ E.coli, colonies of E. coli develop with an intense blue colour - thus making detection and enumeration of this important hygiene indicator as simple as possible.
3. Lighter Workload: Traditional E. coli detection methods are extremely tedious and labor-intensive, requiring experimental studies of many colonies.
4. Quality: CHROMagar™ media contain 5 % more agar than other media on the market. This helps considerably with the application and streaking of the sample onto the plate.
TYPICAL ARREARANCE OF MICROORGANISMS:
E. coli → blue
Other gram negative bacteria → colourless
Gram positive → inhibited
The presence of E. coli indicates faecal contamination and potential presence of dangerous pathogens such as bacteria like Vibrio cholerae, Salmonella, Pseudomonas etc…, or viruses and intestinal parasites. The infections resulting from ingestion of contaminated matter can be dangerous and life-threatening.
Also available in 5000 ml (EC168).